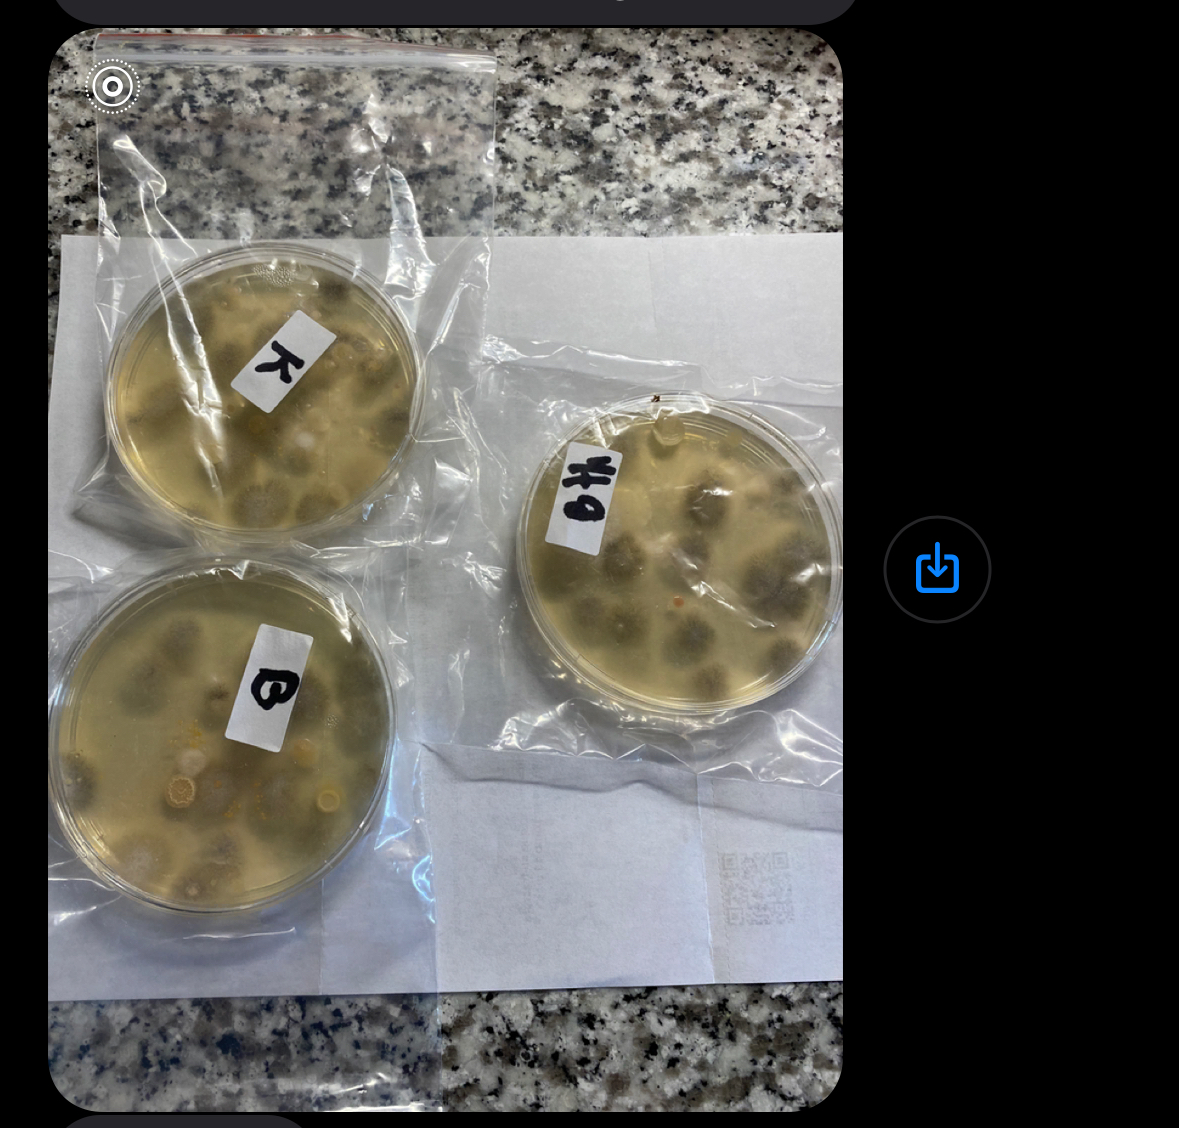
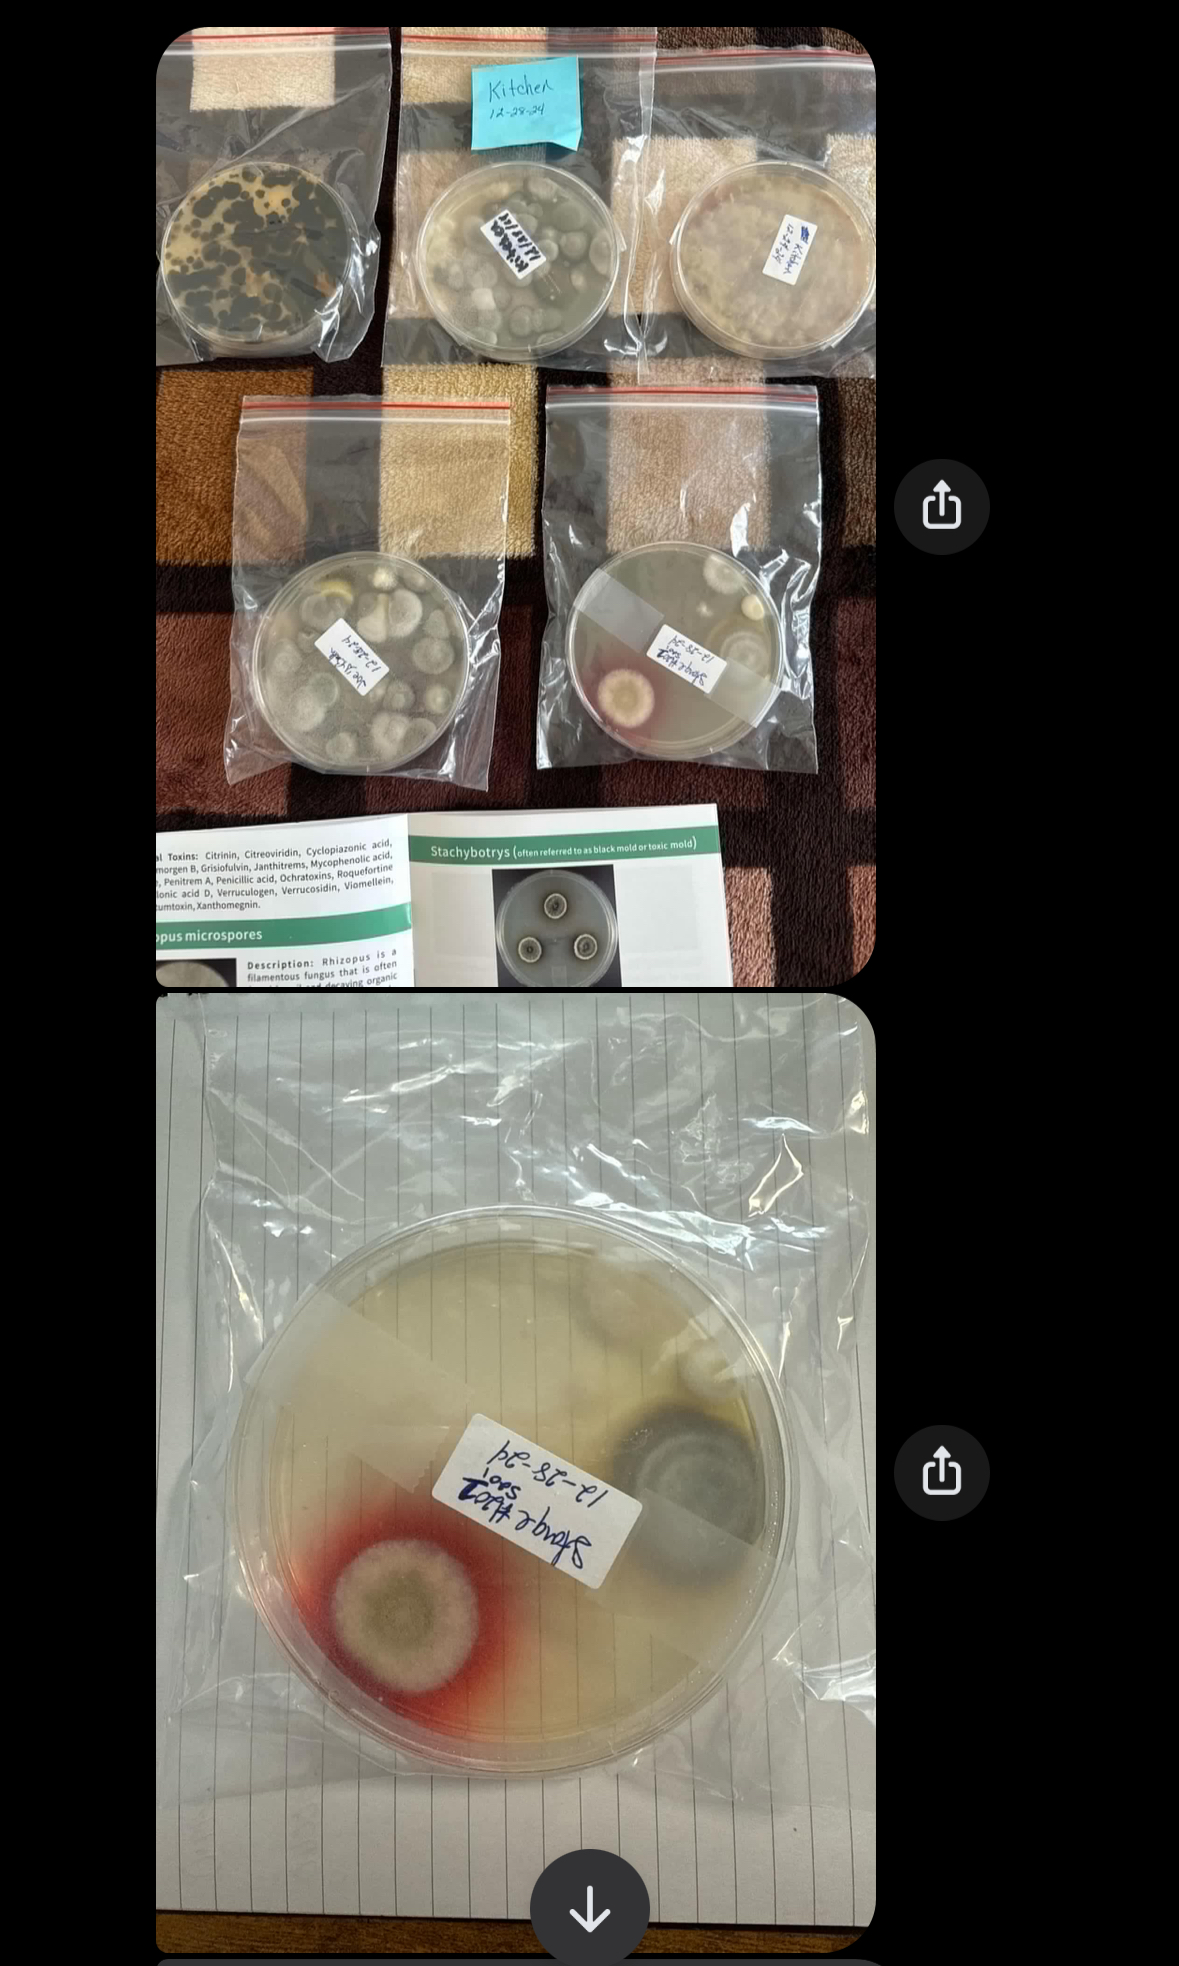
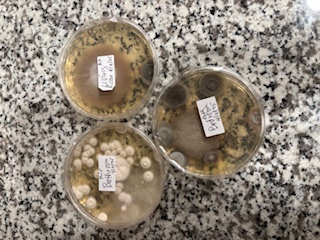

This profile has not been claimed by the business owner or representative.
to update business information, get appointment requests, engage visitors with web chat, and more!
149 Mary Lou Dr, Willow Park, TX, 76087, United States
Get directions| Weekday | Schedule | Status |
|---|---|---|
| Mon | 9:00 a.m. to 6:00 p.m. | |
| Tue | 9:00 a.m. to 6:00 p.m. | |
| Wed | 9:00 a.m. to 6:00 p.m. | |
| Thu | 9:00 a.m. to 6:00 p.m. | |
| Fri | 9:00 a.m. to 6:00 p.m. | |
| Sat | 10:00 a.m. to 5:00 p.m. | |
| Sun | Closed |
I am adding to my initial review as I have 2 more tenants who have shared their mold results, one from 12/24 and the other from today and the Corporation nor the Community Manager will respond or address the issues, they just want to collect money and provide false advertising to the community about this place.

My husband and moved out after fulfilling our lease due to Mold. The manager and corporate team didn't offer us alternate unit or any remedies until 37 days after the initial complaint and after they did their own testing. They offered to come in and "remedy" the mold areas and clean our air ducts after we had already moved. This was in April, now they are threatening to send us to collections for not paying the final inflated bill of charges and fees dated AFTER we had vacated the unit. We have tried calling the corporat... read more
The Preserve at Willow Park has a 4.3 star rating with 43 reviews.
The Preserve at Willow Park is closed now. It will open at 9:00 a.m.
Speak with a specialist to learn how you can grow with Birdeye. We are reachable at profiles@birdeye.com